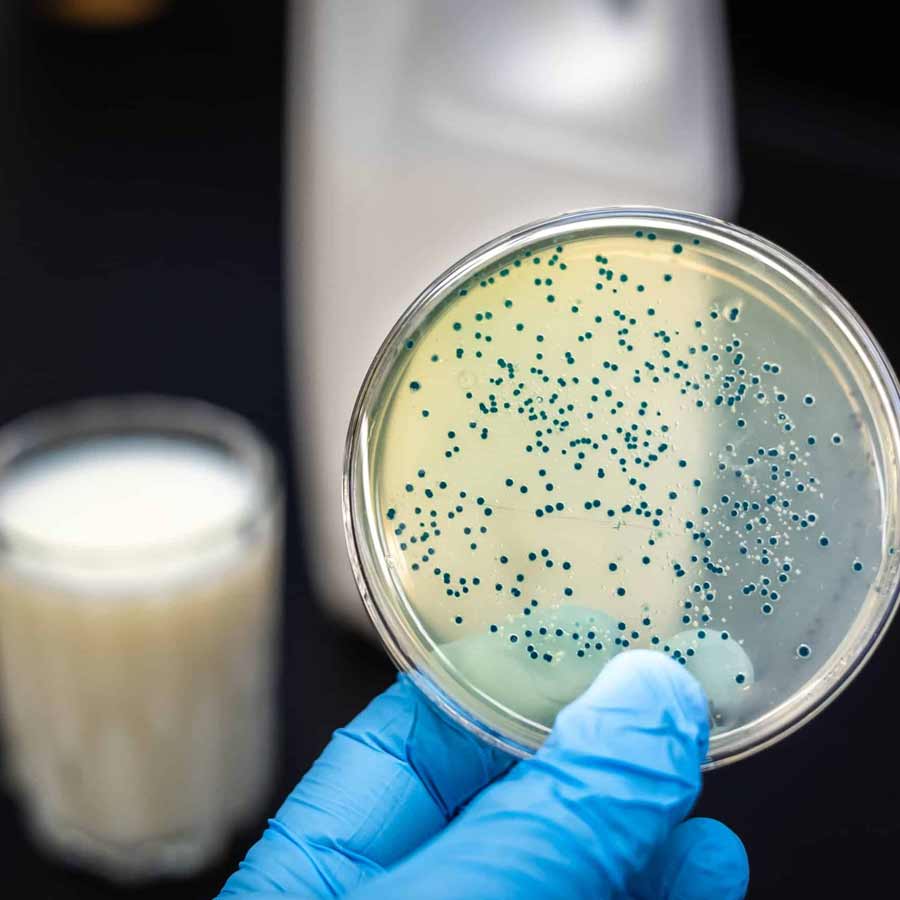
Why does Mark Carney government of Canada decide to increase Vitamin D in milk

আয়োডিনের কায়দায় গোলা হবে ভিটামিন, আমজনতার স্বাস্থ্য ফেরাতে গোদুগ্ধের চরিত্র পাল্টে ফেলছে আমেরিকার প্রতিবেশী!
গোদুগ্ধ প্রক্রিয়াকরণের মাধ্যমে ভিটামিন ডি-র মাত্রা দ্বিগুণ করার সিদ্ধান্ত নিয়েছে আমেরিকার প্রতিবেশী দেশের সরকার। কেন দুধের চরিত্র বদলাচ্ছে তারা?


কানাডায় এ বার ‘শ্বেত বিপ্লব’! দুধের চরিত্র বদল করতে চলেছে অটোয়া। ‘ম্যাপল পাতার দেশ’টির দাবি, এতে আরও বেশি পুষ্টিকর হবে দুধ ও দুগ্ধজাত খাদ্যদ্রব্য। সেই লক্ষ্যে চলতি বছরের ১ জানুয়ারি থেকে সুনির্দিষ্ট একটি প্রকল্পের মাধ্যমে দুধ নিয়ে গবেষণা শুরু করছে তারা। এর পুরোটাই সরকারি অর্থানুকূল্যে চলবে বলে জানা গিয়েছে।


কী ভাবে বদলাবে দুধের চরিত্র? কানাডা সরকার জানিয়েছে, দুধে ভিটামিন ডি-র মাত্রা বাড়াতে চলেছেন তারা। তাতে অবশ্য তরলটির স্বাদ ও গন্ধের কোনও পরিবর্তন হবে না। ২১ শতকে কেন হঠাৎ এই সিদ্ধান্ত নিতে হল, তার ব্যাখ্যা দিয়েছে মার্ক কার্নির প্রশাসন। এর জন্য ‘ম্যাপল পাতার দেশ’টির অস্বাভাবিক ঠান্ডা আবহাওয়াকে দায়ী করেছে তারা।


উত্তর আমেরিকার দেশ কানাডার একটা বড় অংশ সারা বছর ঢাকা থাকে বরফে। শীতকালে আরও খারাপ হয় পরিস্থিতি। ওই সময় রাজধানী অটোয়া-সহ অন্য শহরগুলিতে মারাত্মক ভাবে নেমে যায় তাপমাত্রা। ফলে সারা শরীর মোটা শীতবস্ত্রে ঢেকে রাস্তায় বার হতে হয় সেখানকার বাসিন্দাদের। এ-হেন পারদপতনের জেরে নানা ধরনের স্বাস্থ্যসমস্যার মুখে তাদের পড়তে হচ্ছে বলে জানা গিয়েছে।


শীতকালে রোদের দেখা না পাওয়া এবং যখন-তখন তুষারপাতের জেরে ভিটামিন ডি-র অভাবে ভুগছেন কানাডাবাসীরা। মানবদেহের ত্বক সূর্যালোকের সংস্পর্শে এলে নিজে থেকেই ভিটামিন ডি তৈরি করতে পারে। ত্বকে থাকে ৭-ডিএইচসি নামের একটি উপাদান। সূর্যের আলো পেলে সেটাই ভিটামিন ডি৩-তে বদলে যায়। এই প্রক্রিয়া একেবারেই ঘটছে না ‘ম্যাপল পাতার দেশ’টিতে।


মানুষের হাড়ের স্বাস্থ্য ঠিক রাখার ক্ষেত্রে অত্যন্ত জরুরি একটি উপকরণ হল ভিটামিন ডি। সঠিক পরিমাণে এটা শরীরে তৈরি হলে বাড়ে রোগ প্রতিরোধের ক্ষমতা। একটি সমীক্ষা অনুযায়ী, শীতকালে ৪০ শতাংশ কানাডাবাসীর শরীরে থাকে অপর্যাপ্ত ভিটামিন ডি। গ্রীষ্মকালে এই সংখ্যা কমে নেমে আসে ২৫ শতাংশে।
আরও পড়ুন:


সংশ্লিষ্ট সমীক্ষা অনুযায়ী, পুরুষদের তুলনায় কানাডার মহিলাদের রক্তে তুলনামূলক ভাবে বেশি পরিমাণে ভিটামিন ডি পাওয়া যায়। তবে ২০ থেকে ৩৯ বছর বয়সিদের অবস্থা একেবারেই ভাল নয়। তাঁদের দেহে প্রয়োজনের তুলনায় অনেকটাই কম ভিটামিন ডি পাওয়া গিয়েছে। এই বয়সসীমার ৫৯ শতাংশ যুবক-যুবতী ভিটামিন ডি-র অভাবে ভুগছেন বলা যেতে পারে।


তবে তিন থেকে পাঁচ বছর বয়সিদের ক্ষেত্রে সমস্যাটা প্রায় নেই বললেই চলে। ৮৯ শতাংশ শিশুর দেহে পর্যাপ্ত মাত্রায় ভিটামিন ডি পাওয়া গিয়েছে। ষাটোর্ধ্বদের ক্ষেত্রেও সংখ্যাটা উদ্বেগজনক নয়। তাঁদের ১৮ শতাংশের দেহে ভিটামিন ডি-র অভাব আছে বলে জানিয়েছে ওই রিপোর্ট।


মানবদেহে ভিটামিন ডি-র অভাব হলে একাধিক রোগে আক্রান্ত হওয়ার আশঙ্কা থাকে। এর মধ্যে অন্যতম হল পেশির দুর্বলতা, অবসাদ এবং হাড়ের সমস্যা। শরীরে ভিটামিন ডি-র মাত্রা মারাত্মক ভাবে কমে গেলে সামান্য আঘাতেই ভাঙতে পারে তরুণাস্থি। কানাডাবাসীদের মধ্যে এই ধরনের রোগের প্রকোপ দিন দিন বাড়ছে বলে জানা গিয়েছে।


এই পরিস্থিতিতে দুধকে শক্তিশালী করার সিদ্ধান্ত নিয়েছে মার্ক প্রশাসন। বাধ্যতামূলক ভাবে গোদুগ্ধে ভিটামিন ডি-র মাত্রা দ্বিগুণ করার পরিকল্পনা রয়েছে অটোয়ার। এ ছাড়া দুগ্ধজাত বেশ কিছু খাদ্যদ্রব্যেও ভিটামিন ডি-র মাত্রা বৃদ্ধি করতে চাইছে তারা।
আরও পড়ুন:


বিষয়টি নিয়ে গণমাধ্যমে মুখ খুলেছেন কানাডা প্রশাসনের এক পদস্থ কর্তা। তাঁর কথায়, ‘‘গোদুগ্ধকে সুষম খাবার বলা যেতে পারে। অর্থাৎ, এতে সমস্ত ধরনের ভিটামিন এবং খনিজ দ্রব্য থাকে। তবে আমাদের আমজনতার জন্য সেটা পর্যাপ্ত নয়। আর তাই প্রক্রিয়াকরণের মাধ্যমে এতে ভিটামিন ডি-র মাত্রা বৃদ্ধি করে তবে তা বাজারে বিক্রির সিদ্ধান্ত নেওয়া হয়েছে।’’


সূত্রের খবর, গোদুগ্ধে ভিটামিন ডি৩-র মাত্রা বাড়াতে প্রক্রিয়াকরণের সময়ে এতে কোলেক্যালসিফেরল মেশানোর পরিকল্পনা করেছে কানাডা প্রশাসন। সেই দুধ পান করলে মানবত্বক নিজের থেকে প্রয়োজনমতো ভিটামিন ডি তৈরি করে নিতে পারবে বলে জানিয়েছে কার্নি সরকার। দুধে এর সুষম বণ্টন নিশ্চিত করতে ভিটামিন ডি খুব অল্প পরিমাণে চর্বিতে দ্রবীভূত করতে পারে অটোয়া।

স্থানীয় গণমাধ্যমগুলি জানিয়েছে, দুধ প্রক্রিয়াকরণের এই প্রক্রিয়াটির উপর পুরোপুরি নিয়ন্ত্রণ থাকবে সরকারের। ভিটামিন ডি-র মাত্রা বাড়াতে গিয়ে দুধে যাতে অন্য ধরনের কোনও রাসায়নিক বিক্রিয়া না ঘটে বা দুধ যাতে বিষাক্ত না হয়ে যায়, তাই এই ব্যবস্থা। দুধের সামগ্রিক গঠন অপরিবর্তিত রেখে এই প্রক্রিয়াকরণ করবে অটোয়া।


গবেষকদের দাবি, প্রাকৃতিক ভাবে তৈরি ভিটামিন ডি-র সঙ্গে রাসায়নিক বা জৈবিক ভাবে তৈরি ভিটামিন ডি-র কোনও পার্থক্য নেই। ফলে কানাডা সরকারের সিদ্ধান্তকে ‘হাস্যকর’ বলা যাবে না। তবে দুধ প্রক্রিয়াকরণের সময় অটোয়াকে একটি বিষয় খেয়াল রাখতে হবে। সেটা হল, এর জন্য নিজের থেকে দুধের অন্য কোনও চরিত্র বদল হচ্ছে কি না। আমজনতার স্বাস্থ্যের জন্য সেটা বিপজ্জনক হতে পারে।


কার্নি প্রশাসনের এই সিদ্ধান্তের নেপথ্যে আর একটি যুক্তি হল, এর জন্য খাদ্যাভাসে কানাডাবাসীকে আনতে হবে না কোনও বদল। আগের চেয়ে আরও পুষ্টিকর খাবার পাবেন তাঁরা। অটোয়া জানিয়েছে, ভিটামিন ডি-যুক্ত দুধ আধুনিক সময়ের খাদ্যের জটিল চ্যালেঞ্জগুলির সমাধান করবে না। এটি কেবল গুরুত্বপূর্ণ অনুসারক হিসাবে কাজ করবে।


বিশ্বে দুধ উৎপাদনে প্রথম পাঁচে নেই কানাডা। সেখানে জায়গা পেয়েছে ভারত, মার্কিন যুক্তরাষ্ট্র, পাকিস্তান, গণপ্রজাতন্ত্রী চিন (পিপল্স রিপাবলিক অফ চায়না) এবং ব্রাজ়িল। তার পরেও উত্তর আমেরিকার দেশটির দুগ্ধশিল্প বেশ উন্নত। কানাডার কুইবেক ও অন্টারিও প্রদেশ প্রধান দুগ্ধ উৎপাদন কেন্দ্র হিসাবে পরিচিত।


১৯২৪ সালে আয়োডিনযুক্ত লবণ বাজারে আনে মার্কিন যুক্তরাষ্ট্র। মানবস্বাস্থ্যের কথা ভেবে পরবর্তী কালে নুনের চরিত্র বদলায় বিশ্বের প্রায় প্রতিটি দেশ। এ বার দুধের উপর তা করতে চলেছে অটোয়া। তবে এর জন্য দুধের দাম বৃদ্ধির সম্ভাবনা যে বাড়ছে, তা বলাই বাহুল্য।







